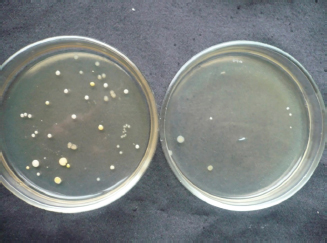

| Research Article | ||
Open Vet. J.. 2023; 13(8): 991-1002 Open Veterinary Journal, (2023), Vol. 13(8): 991-1002 Original Research The use of a homeopathic preparation in the treatment of subclinical form of mastitis in cowsAigerim Kukeyeva*, Talgat Abdrakhmanov, Gulzhan Yeszhanova, Zhanar Bakisheva and Zhomart KemeshovDepartment of Veterinary Medicine, S. Seifullin Kazakh Agro Technical Research University, Astana, Republic of Kazakhstan *Corresponding Author: Aigerim Kukeyeva. Department of Veterinary Medicine, S. Seifullin Kazakh Agro Technical Research University, Astana, Republic of Kazakhstan. Email: aigerimkukeyeva48 [at] gmail.com Submitted: 02/05/2023 Accepted: 25/07/2023 Published: 31/08/2023 © 2023 Open Veterinary Journal
AbstractBackground: Mastitis is a disease of productive cows, widespread throughout the world, and characterized by significant economic damage to the dairy industry. The subclinical form of this disease is aggravated by additional difficulties with its diagnosis and the lack of clear treatment protocols. Aim: Therefore, the study of the effectiveness of diagnostic studies and the search for new methods of treatment of latent forms of mastitis is an important direction in scientific research in countries with developed dairy cattle breeding. Methods: Studies conducted on the number of dairy cows of the production cooperative “Izhevsky” of the Akmola region of the Republic of Kazakhstan showed that when using rapid tests Kenotest, Somatest, Mastidine test, and Wideside test, the same results were obtained when the disease was detected in cows. The effectiveness of the tests was at the level of 60%–62% when using the settling sample as a control. Medical procedures were carried out using the Aquaton-2 microwave radiation apparatus and a homeopathic preparation. When using physiotherapy with microwave radiation, a decrease in the level of microbial contamination of milk from the treated part of the udder by 1.5–5 times was observed. Results: Biologically active substances of plant origin in the homeopathic preparation, due to the immunostimulating effect, made it possible to increase the level of γ-globulins in the blood serum of sick animals during the application. Conclusion: The complex use of both methods in the treatment of animals with a subclinical form of mastitis made it possible to reduce the level of somatic cells in the milk of the affected udder lobe to a level that cannot be determined using Kenotest in 4–6 days, which is 2–4 days faster than using these methods separately. Keywords: Somatic cells, Physiotherapy, Biochemical indicators, γ-globulins, Diagnostic tests. IntroductionThe main task of the national food program of any country is to provide the population with high-quality and safe food products, including those of animal origin. Therefore, control over the productive health of animals from which raw materials for food production are obtained and constant monitoring of product quality is a paramount task for all links of veterinary and sanitary control, both at the stage of obtaining raw materials and at the stage of production of finished products. Milk and dairy products have always been one of the key foods in the human diet. They contain almost all the necessary elements in an easily accessible form for the normal functioning of the human body. However, this is true only for high-quality products, while low-quality milk or products made from it, on the contrary, can harm the health of the consumer (Dikhanbayeva et al., 2019). Mastitis, a widespread disease, leads to a reduction in milk quality and renders it generally unsuitable for consumption due to inflammation of the mammary gland, which causes physicochemical changes in milk and pathological changes in the udder parenchyma. This disease is common mainly among dairy cows and can occur regardless of the season of the year or the stage of lactation, the conditions of keeping, or the breed of animals (Zhumanov et al., 2015). The causes of its occurrence are also very diverse from infectious diseases to non-compliance with elementary hygiene rules when preparing cows for milking. Such diverse causes lead to the widespread of this disease among the population of dairy cows in the Republic of Kazakhstan (Kelm, 2021). The problem of cows with mastitis is also exacerbated by the fact that, compared with clinical mastitis, which is easy to identify by a set of signs and treat promptly, the subclinical form of mastitis occurs much more often among livestock and, according to some authors, causes more economic losses of dairy cows industry (Kumari et al., 2018; Chuzhebayeva et al., 2021; Ranasinghe et al., 2021). Diagnosis of the subclinical form of mastitis in cows is difficult due to the lack of clinical signs of the disease and it can be detected only by applying additional laboratory methods (Proshutinskaya and Neverova, 2019). The main changes occur in the quantitative and qualitative composition of milk—this is an increase in the number of somatic cells, an increase in the acidity of milk, and a decrease in the amount of casein, lactose, and other components of milk (Kandeel et al., 2019; Leitner et al., 2019; Antanaitis et al., 2021). The most problematic links in the treatment of subclinical mastitis are the timely diagnosis of the disease in the conditions of the production process and the use of effective approaches to eliminate the inflammatory process in the mammary gland of a productive animal. For diagnostics, several approaches are used, the action of which is based on the principles: counting the number of somatic cells—microscopically (Mustafin and Volkov, 1984; Robles et al., 2021) and cytological method (Zecconi et al., 2019; Zhelavskyi, 2021; Rienesl et al., 2022), microbiological examination of milk (Adkins and Middleton, 2018), electrical conductivity (Ebrahimie et al., 2018), the concentration of hydrogen ions (pH) (Kandeel et al., 2019), breast thermography (Velasco-Bolanos et al., 2021), and rapid tests based on visual effects (Kandeel et al., 2018; Sinha et al., 2018; Nagasawa et al., 2020). Diagnostic tests are the most widespread in production conditions. This is due to the simplicity of the analysis and the rapid accounting of the results of the study. Of the most well-known tests that are used on farms, they use the California test, Masttest, Ecotest, KerbaTest, Kenotest, ReagentN, and a number of others. The action of rapid tests is based on a change in the viscosity of milk, with a high content of somatic cells, under the action of a reagent. The composition of the reagent includes components that cause cell lysis and a pH indicator. As a substance that destroys the membranes of somatic cells, surfactants are used, which increase the viscosity of milk. The indicator changes the color of the milk if the pH rises, as happens with severe mastitis. Thus, rapid tests simultaneously use two characteristics of mastitis milk, which increases the reliability of the results obtained (Shakhnovich, 2020). The effectiveness of the tests is confirmed by a high correlation with the results of somatic cell counts and bacteriological studies (Niyongabo et al., 2021). The viscometric method for determining the number of somatic cells is based on the same principle (Mironchik and Babayants, 2021). Thus, all tests determine the approximate number of somatic cells in milk, which correlates with the degree of manifestation of mastitis. Depending on the manufacturer, the sensitivity of the tests varies slightly, this is due to the chemical formula and the quality of the reagents. So, most tests for determining mastitis “work” at a concentration of somatic cells from 150,000 to 200,000. The comparative use of tests in the work of Chernenok et al. (2019) concluded that the sensitivity of the Kenotest is significantly higher than that of the Masttest and Ecotest. Belagrogen’s tests were found to be one of the more sensitive ones. The test kit Somatic-plus proved to be effective at the content of somatic cells in milk from 100,000, and Somatic-expert at 150,000 cells/ml. Laushkina et al. (2020) indicated that the tests KerbaTest, Kenotest, and settling test are reliable methods for diagnosing subclinical mastitis. Recently, a large number of diagnostics have been proposed for the diagnosis of mastitis; choosing the most effective of them is one of the tasks of this study. An equally important step is the treatment of animals with inflammation of the mammary gland. If clinical mastitis is treated with antimicrobial and non-steroidal anti-inflammatory drugs, subclinical forms of mastitis are usually not given much attention (Sharun et al., 2021). Although, at the same time, there is also a decrease in productivity in cows, and they can serve as a source of infection for other animals (McDougall et al., 2022). Therefore, for therapeutic purposes, different authors use physiotherapy: Leitner et al. (2021)—acoustic impulses; Lubimov et al. (2020)—frequency and resonance therapy; and Moreira et al. (2018)—photodynamic therapy. In another case, homeopathic preparations are used: Imam et al. (2021) and Ajose et al. (2022)—a mixture of plant compounds; Yang et al. (2019)—Angelica and Rheum extracts; Larionov et al. (2019)—ichthyol ointment and trauma gel; Zainettinova et al. (2019)—a complex of antimicrobial and vitamin preparations; and Mukhamadieva et al. (2022)—ASD + sea buckthorn oil. Therefore, the search for an effective method of treatment remains an important area of scientific research. The use of only such cellular and biochemical markers of subclinical mastitis complicates the diagnosis of the disease among animals on farms, as they require expensive equipment, and takes a significant time to make a diagnosis. Therefore, to test animals for latent mastitis, specific diagnostic tests are used, which in a matter of minutes allow, with a high degree of probability, to determine the development of the inflammatory process in the mammary gland parenchyma, even before the manifestation of the clinical form of the disease. The advantage of early diagnosis of mastitis, in addition to monitoring the quality of raw milk during its production, is a simpler and more effective approach to treating the disease at an early stage (Shukesheva et al., 2018). This avoids the use of antimicrobials with prolonged action and a long withdrawal period, which also reduces the technological characteristics of milk. Therefore, in the treatment of the subclinical form of mastitis, it is recommended to use non-drug methods of treatment or the use of homeopathic preparations that can shorten the period of the disease and use milk for on-farm use. The topic of subclinical mastitis is highly relevant due to its significant impact on the dairy industry. The disease not only causes economic losses through reduced milk production and poor milk quality but also poses challenges in terms of accurate diagnosis and appropriate treatment protocols. The purpose of the research was to assess and compare the effectiveness of diagnostic tests for identifying subclinical mastitis in cows, and to evaluate the efficacy of homeopathic and physiotherapy treatments as alternative approaches for managing mastitis, in comparison to traditional treatment methods. The novelty of this study lies in its comprehensive approach, combining the evaluation of rapid diagnostic tests, the assessment of microwave radiation therapy, and the examination of a homeopathic preparation for subclinical mastitis. Materials and MethodsSome statistical methods were used to describe the statistics in this paper. Analysis of variance allowed us to compare averages across years or treatment groups. Regression analysis allowed us to examine the relationship between variables, such as hygiene practices and mastitis prevalence. Hypothesis testing allowed us to compare averages or proportions between groups, such as comparing mastitis prevalence between different breeds of cows or treatment outcomes between groups. The research work was carried out within the framework of the scientific research program of S. Seifullin Kazakh Agrotechnical University, the National Center for Monitoring, Reference, Laboratory Diagnostics and Methodology in Veterinary Medicine, the State Inspection Committee in the Agro-Industrial Complex of the Ministry of Agriculture of the Republic of Kazakhstan and the Institute of Applied Chemistry L. N. Gumilyov Eurasian National University. The experimental part of the study was carried out on the number of dairy cows of the production cooperative “Izhevsky” of the Akmola region. Comparative performance of diagnostic tests for subclinical mastitis was carried out using rapid tests Kenotest, Somatest, Mastidine test, Wideside test, and settling. When studying milk samples using Kenotest, Somatest, and Mastidine, 2 ml of the solution was poured into a tablet or test plate, and 2 ml of the studied milk from each part of the udder was added to it, the mixture was mixed with a stick and the result was evaluated by color and consistency. When using the above tests, the reaction was recorded after 10 seconds. If the milk mixture remained homogeneous and the color of the mixture did not change, the reaction was considered negative (−). A positive reaction (+) is if the mixture of milk and diagnostic forms a jelly-like consistency and the color of the solution changes (Figs. 1 and 2).
Fig. 1. Photo of Kenotest and recording the results of its use.
Fig. 2. Photo of Somatest and recording the results of its use. This study was employed using the Whiteside method, where a 4% sodium hydroxide solution was mixed with milk in a ratio of 1:5. With mastitis, a thick viscous mass with flakes is formed. During the settling test, from each share of the udder of cows that showed a positive reaction with the express test, 10–15 ml of milk was poured into test tubes and left in the refrigerator for 16–18 hours. In the milk of cows sick with mastitis, in the process of settling at the bottom of the test tube, sediment appeared, if it is higher than 0.1 cm, then the cows were considered sick with mastitis. According to the results of diagnostic studies using Kenotest, 15 cows with a subclinical form of mastitis were selected, which were divided into 3 groups of 5 animals each. Control group—animals of this group were treated according to the scheme adopted on the farm. Mastometrin was injected subcutaneously at a dose of 5 ml, two times a day, for 2, 4, and 6 days of treatment. Physiotherapy was carried out using the Aquaton device, two times a day with an exposure of 10 minutes (daily), the radiation source was placed at a distance of 15–20 cm from the skin of the affected area of the udder. Massage the udder two times a day by rubbing ichthyol ointment into the affected parts of the udder (Fig. 3). The difference in the treatment of animals in the first experimental group from the control group was the replacement of Mastometrin with a homeopathic preparation developed at the Department of Veterinary Medicine S. Seifullin Kazakh Agrotechnical University, which was administered in doses and according to the Mastometrin scheme, and an increased exposure to microwave radiation for 20 minutes. Animals of the second experimental group, in comparison with the first group, did not undergo physiotherapy using the Aquaton device.
Fig. 3. Aquaton device for treating cows with subclinical mastitis. The treatment of cows was monitored using Kenotest, as well as a biochemical blood test. Microbiological studies were carried out using the procedure of inoculation on nutrient media with a further determination of the type of microorganisms. In blood tests, an automatic hematology analyzer MicroCC-18 was used, and the protein content in blood serum was determined using an IRF-22 refractometer (Fig. 4). Ethical approvalThis study has been reviewed and approved by the Ethical Review Committee of S. Seifullin Kazakh Agro Technical Research University (approval number: KATRU-2023-001). ResultsMastitis is an inflammatory condition that affects the mammary gland, primarily in dairy cows but can also occur in other mammals, including humans. It is one of the most common and costly diseases in the dairy industry, impacting milk production and quality. The causes of mastitis include bacterial infections, such as Staphylococcus aureus, Streptococcus species, and Escherichia coli, which can enter the mammary gland through the teat canal. Other factors contributing to mastitis include poor milking hygiene, inadequate teat disinfection, environmental contamination, improper teat end closure, and compromised immune function of the cow. The first stage of the work was to conduct a comparative performance of test systems for the determination of subclinical mastitis in cows, which is widespread in Kazakhstan. The following tests were used in the work: Kenotest, Somatest, masti dine test, and the Whiteside method. As a control for the incidence of animals, the results of the settling test were used. The results of the study of milk samples from cows with diagnostic tests are presented in Table 1. The conducted studies of milk samples with tests for subclinical mastitis and a parallel settling test as a control indicate that all express tests presented showed efficiency at almost the same level. For all tests, the percentage of detection of latent mastitis was about 60%. A slight increase in the percentage of animals with a subclinical form of the disease when using the masti dine test was within the error, and probably, with an increase in the number of animals in the test group, it would be at the level of other tests. The relative error of the settling test itself should also be noted since there is no clear correlation between the number of somatic cells in milk and the height of the sediment during milk settling. In addition, this method does not take into account the presence of technological impurities that may enter the milk from the milking equipment or the milk pipeline. Also, the evaluation of the results of express diagnostics is a subjective method that is not without the possibility of human error. These shortcomings, when using tests for the latent form of mastitis, do not allow to guarantee the presence or absence of the disease with high accuracy. In the following studies, quantitative methods for determining mastitis, microscopic somatic cell counting, or flow cytometry should be used as a control to more accurately determine the incidence. In the second stage of the work, the influence of physiotherapy and homeopathic preparations on the duration of treatment in subclinical mastitis was analyzed. Of the physiotherapeutic procedures, microwave radiation of the affected part of the udder was used in the treatment, which was created using the Aquaton-2 parting. This method was chosen due to the possibility of local normalization of blood microcirculation and metabolism in tissues after exposure to microwave radiation, which will reduce the level of inflammation. In addition, radiation also had a pronounced antibacterial effect on the udder microflora and had a positive effect on the immune system, which is especially important from the point of view of the microbial cause of the disease. Therefore, the use of physiotherapy increased the effectiveness of treatment. The intensity and frequency of use of the Aquaton-2 device for the treatment of subclinical mastitis was calculated from the recommended and maximum allowable doses of tissue irradiation in a chronic process, specified in the instructions for use of the device. Changes in the number of microorganisms in the milk of the control group of cows before and after treatment of the affected part of the udder for 10 minutes are shown in Table 2.
Fig. 4. Blood sampling for biochemical research. Table 1. Results of the study of milk samples from cows using various diagnostic tests (n=60).
Table 2. The content of microflora in the milk of cows of the control group after treatment of the udder using the Aquaton-2 device.
As a result of such a physiotherapeutic procedure, the total number of microorganisms in milk decreased by 1.7 times, and hemolytic microorganisms by four times. An even greater bactericidal effect was obtained as a result of a 20-minute exposure to microwave radiation on the mammary gland in animals of the first experimental group. This is the maximum recommended dose of such radiation in the treatment of cows with chronic mastitis. After physiotherapy of such intensity and exposure, there was a decrease in the total bacterial contamination of milk [according to the mesophilic aerobic and facultative anaerobic microorganisms (MAFAM) indicator] from the affected quarter of the mammary gland by five times compared with animals in which such a procedure was not carried out and by 1.5 times with the treatment of cows with an exposure of 10 minutes (Table 3). The conducted studies showed that longer microwave irradiation of the affected areas of the mammary gland was accompanied by a more pronounced bactericidal effect on the microflora, which was seen in the reduction of microbial contamination of milk in sick cows. This is confirmed by the number of grown colonies from cultures of milk samples before and after the physiotherapy procedure for 10 and 20 minutes on meat-peptone agar (MPA) (Fig. 5). The decrease in the number of MAFAMs, as an analog of the indicator of the total number of microorganisms in milk, is a marker of the effectiveness of the chosen method for the treatment of subclinical forms of mastitis in productive animals. Since such a decrease in the number of viable microorganisms occurs simultaneously both in milk and in the mammary gland, which positively affects the dynamics of the treatment of cows. An equally effective approach in the treatment of mastitis was the use of a homeopathic preparation developed at the Department of Veterinary Medicine S. Seifullin Kazakh Agrotechnical University. The drug is an ethyl-water extract from medicinal plants with antimicrobial, anti-inflammatory, and immunostimulating effects. Also, the composition of the homeopathic preparation includes a complex of biologically active substances with restorative properties. This drug was used in the animals of the experimental groups, while in the control group, the homeopathic drug Mastometrin (Helvet company) was used in the same dosage and according to a similar regimen that met the recommendations for the use of this drug. Mastometrin is widely used in veterinary practice for the treatment of subclinical and latent forms of mastitis in animals. As a result of the use of the drug developed at the Department of Veterinary Medicine S. Seifullin Kazakh Agrotechnical University, the animals of the experimental groups showed a negative test for mastitis (Kenotest) a few days earlier than the cows of the control group (Table 4). Table 3. The content of microflora in the milk of cows of the first experimental group after treatment of the udder using the Aquaton-2 device.
The presented tabular material shows that the animals of the experimental groups had better treatment dynamics than cows that received traditional treatment for the farm. Even despite the complex antimicrobial action of the homeopathic remedy and the physiotherapeutic treatment of animals in the control group, the cows that received only the homeopathic remedy (the second experimental one) recovered 2 days faster. Thus, the homeopathic preparation developed by the staff of the Kazakh Agrotechnical University is an effective therapeutic drug in the treatment of animals with a subclinical form of mastitis. For a more detailed analysis of the mechanism of the therapeutic action of a homeopathic preparation on the body of cows, a number of biochemical studies of the blood of controlled animals were carried out. Blood was examined from three animals from each group. The first blood sampling was carried out on the day of diagnosis, and the second—on the day of receiving a negative Kenotest after treatment. The results of the study are presented in Table 5. An analysis of the biochemical parameters of the blood serum of controlled cows shows that the disease of subclinical mastitis does not significantly affect the blood system of animals. One of the indicators, the reference indicators of which were below the physiological norm, was the glucose content. But, for highly productive animals during the first half of lactation, such indicators are normal (Khastayeva et al., 2021). The concentration of glucose in the blood of cows was below the norm by 39.6%–40.5%. After treatment, there was an increase in the dynamics of glucose levels in all experimental groups. In the first group, the glucose level increased by 22.1%, in the second group—by 27.48%, and in the third group—by 22.35%, but in the treatment area this indicator did not reach the physiological level.
Fig. 5. The number of colonies grown on MPA before and after the physiotherapy procedure. Table 4. Terms of recovery of cows of the control and experimental groups.
Table 5. Results of biochemical studies of blood serum of cows before and after treatment of subclinical mastitis.
In addition, a more indicative therapeutic effect of homeopathic preparations is the positive dynamics of the content of total protein indicators and direct fractions—β and γ-globulins, which are responsible for the protective properties of the body. Due to the increase in the content of the globulin fraction in the blood, a decrease in the proportion of albumins was observed. Among the controlled groups, the amount of β—globulins in the blood of cows of the first group did not change significantly, in the second group the concentration increased by 18.39%, and in the third group—by 8.84%. It should be noted that at the beginning of treatment, the concentration of gamma globulins was at the minimum level of the physiological norm. After treatment, a significant increase in the level of γ-globulins in the blood was revealed in all experimental groups. In the first group, the concentration of γ-globulins increased by 3.27%, in the second group—by 5.16%, and in the third group—by 3.92%. The concentrations of macronutrients calcium and phosphorus in the blood serum also had a positive trend in the course of treatment. The initial level of calcium in the blood of sick animals was below normal in all controlled groups. Before treatment, the calcium concentration in the blood of cows was 26.0%–29.2% lower than physiological parameters. As a result of treatment, the calcium level rose by 9.4%, 12.2%, and 11.5% in the control, first, and second experimental groups, respectively. The content of phosphorus, both before and after treatment, remained within the physiological limits and showed a slight increase during treatment. The results of the conducted studies show the high efficiency of the use of a homeopathic preparation for the treatment of subclinical mastitis, both independently and in combination with a physiotherapeutic method. According to Mukhamadieva et al. (2022), the average clinical mastitis was detected in 35.4% of cows in 2016, 19.6% in 2017, 28.5% in 2018, and 16.4% of cows in 2019. In turn, in Northern Kazakhstan, a study was conducted, the result of which was the detection of Staphylococcus aureus from dairy cows of such breeds as Simmental and black-and-white. According to the results, 12.5% (16/128) were isolated from Simmental cows and 9.3% (48/515) from black-and-white cows (Rychshanova et al., 2022). Regional differences in mastitis prevalence can be influenced by various factors, including agricultural practices, local environmental conditions, and breed distribution. In the mentioned study, the prevalence of clinical mastitis varied over different years, indicating potential temporal variations in management practices or environmental factors that could impact mastitis incidence. These findings highlight the complex interplay between regional factors and mastitis occurrence. Several effective hygienic prevention practices are used to prevent mastitis in the dairy industry, which includes proper milking procedures, maintaining a hygienic milking environment, disinfecting teats after milking, culling infected cows, implementing environmental management practices, ensuring cow hygiene, and using appropriate vaccination strategies. The current implementation of these practices in the dairy industry in Kazakhstan requires information from local sources such as dairy industry associations, veterinary services, or scientific studies to evaluate their implementation and compliance with these hygiene practices. Education and training play a crucial role in the prevention, diagnosis, and treatment of mastitis in dairy cows for both farmers and veterinarians. For farmers, proper education and training programs can enhance their understanding of mastitis prevention strategies, including effective hygiene practices, proper milking techniques, and regular udder health monitoring. This knowledge empowers farmers to implement proactive measures, such as maintaining a clean and hygienic environment, practicing good milking hygiene, and promptly identifying and addressing early signs of mastitis. Education can also help farmers understand the importance of timely veterinary intervention and the appropriate use of medications when necessary. Similarly, veterinarians benefit from continuous education and training to stay updated on the latest advancements in mastitis prevention, diagnosis, and treatment. This includes gaining knowledge about emerging pathogens, diagnostic methods, and treatment protocols. Veterinarians can provide valuable guidance to farmers, including conducting on-farm training sessions, assisting in the development of mastitis prevention plans, and offering advice on proper treatment strategies. Additionally, veterinarians can contribute to research and collaborative efforts to improve mastitis management practices. The combined treatment of homeopathic medicines and physiotherapy shows faster recovery times, while microwave radiation using the Aquaton-2 apparatus exhibits antimicrobial effectiveness. Future research should focus on optimizing treatment timing for the Aquaton-2 device and further exploring subclinical mastitis management. DiscussionMastitis is one of the most economically costly diseases in livestock production, causing significant financial losses on dairy farms around the world (Kumari et al., 2018). This disease is recorded in most productive cows during the active phase of lactation, even in those farms where the required hygiene procedures are carried out. Inflammation of the udder in cows is often regarded as the biggest problem of the dairy industry, which leads to both financial losses and negative consequences in the technological processing of milk and a possible impact on the health of consumers (Zainettinova et al., 2019; Gritsienko et al., 2022). During lactation, a disease of only one lobe of the udder can reduce milk yield by at least 10%. In addition, mastitis is also one of the causes of premature culling of dairy cows. Thus, the financial losses associated with mastitis depend on a significant set of various factors associated with the treatment of animals, shortfalls in production, and forced culling of cows (Neculai-Valeanu and Ariton, 2022). Unfortunately, the previous information relates to a greater extent to the clinical form of mastitis, while much less attention is paid to the subclinical or latent form of mastitis. This is due to a number of difficulties in identifying sick animals. Not all farms conduct periodic studies of the health of the mammary gland of cows in the herd, and a decrease in milk production is associated with seasonality or on-farm reasons (Gryshchenko et al., 2016). Existing tests in Kazakhstan for detecting subclinical forms of mastitis in animals turned out to be quite effective, and as a result of the studies, they showed almost the same diagnostic level. Although the studies of Shakhnovich (2020), Niyongabo et al. (2021), and Chernenok et al. (2019) pointed out significant differences in the efficiency of detection of subclinical mastitis in animals. A possible explanation for this is the different methods of residual determination of the incidence of animals. Most of the previous authors focused on the number of somatic cells, and in this study, the settling test was the control method, which itself has a certain margin of error. In this work, this was used due to a significant difference in the normative documents for the number of somatic cells in milk, which is allowed for industrial processing. Thus, Regulation (EC) No. 853/2004 of the European Parliament and of the Council (2021) on the establishment of special hygiene rules to be applied to food products of animal origin, stipulates that the maximum number of somatic cells should not exceed 400 tis/ml. Whereas in Kazakhstan there are the Technical Regulations of the Customs Union “On the Safety of Milk and Dairy Products” (2013), which provides for a maximum cell content of 750 tis/ml. The article used rapid tests focused on a European manufacturer, therefore, the results obtained were compared with the results of a reference test—a settling test. For greater information content when working with tests in future studies, it is planned to correlate the category of evaluation of test results with quantitative indicators of somatic cell content limits. This will allow reviewing the effectiveness of tests for the dairy industry, but for now, all the tests taken in the study—Kenotest, Somatest, Whiteside test, and Mastidine test are recommended for use on dairy farms equally. The use of more sensitive tests in the work triggered at a concentration of somatic cells from 100,000 cells/ml, which is considered by Shakhnovich (2020) as an advantage, is not really appropriate. Since they can cause a false positive reaction, which, given the subjectivity of the assessment of test results, is even undesirable and may entail additional costs for unnecessary treatment. The results of such highly sensitive tests have contributed to the development among veterinarians and pet owners of the wrong opinion about the inappropriateness of treating animals with subclinical mastitis. Since the main changes in the latent form of mastitis occur only in terms of milk, animals are treated mainly by farms with their own processing facilities so that they do not affect the quality of the products. While the farms that deliver raw milk to milk processing enterprises pay little attention to the diagnosis and treatment of animals with a subclinical form of mastitis, they retain a source of infection that contributes to its further spread among the livestock of the farm. The lack of uniform norms for the permissible content of somatic cells in milk in the regulatory documents of different countries confuses both the diagnosis and treatment of subclinical mastitis (Williamson et al., 2022). Many approaches have been developed in the treatment of latent mastitis, but almost all of them do not involve the use of antibiotics in therapy (Costa et al., 2021). Since it is believed that the body itself can cope with such a “minor” disease. On the other hand, inexpensive drugs and approaches are used to save on treatment, and the recovery of animals is stretched for a long time. Although, most studies agree that the primary cause of the increase in the number of somatic cells in milk, and hence the occurrence of subclinical mastitis, is the activation of pathogens in the tissues of the mammary gland. Therefore, Borne et al. (2019) recommend using a differentiated approach in the use of antimicrobials in the treatment of such diseases, another question is which class of antimicrobials they belong to and which routes of their excretion from the body are involved. The work studied the effect of therapy from the use of the most common approaches in Kazakhstan in the treatment of latent mastitis, the use of physiotherapy and homeopathy. The mechanisms of their action are associated with an increase in the body’s defenses, improvement of local metabolism in the area of inflammation, activation of the cellular and humoral response of the immune system, acceleration of the elimination of inflammatory products from the body, direct antimicrobial action, and other therapeutic effects both at the local level and at the level of the whole organism (Bulegenova et al., 2019). An additional advantage of using such approaches in the treatment of subclinical mastitis is the absence of unwanted drugs in milk, which are found when antibiotics are used. Since milk containing residual amounts of antibiotics is prohibited from being used for food production, these substances also reduce the activity of starter cultures and other microbiological products used in the technological process of milk processing (ST RK 1760-2008, 2008). Each of the approaches used in the treatment of latent mastitis turned out to be an effective tool, which is confirmed by the results of studies and other authors. So, the results of microwave radiation on the course of mastitis in animals are confirmed by the works of Rahimzhanova et al. (2020) and Semivolos (2011). Treatment of the affected lobe of the mammary gland, carried out using the Aquaton-2 device, contributed to a 1.5–5-fold decrease in the total bacterial contamination of milk, and hence a decrease in the number of microorganisms in the parenchyma of the udder of cows. No less therapeutic effect was found when using homeopathic medicines. Considering the diverse effect of medicinal plants included in the preparation on the body of a sick animal, it was possible to accelerate their recovery by 2–4 days compared to the control group of cows. But the best therapeutic effect was the combined use of both approaches. Thanks to the combination of therapeutic approaches in the treatment of controlled animals, cows were completely cured within 4–6 days, which in itself is an excellent result in the inflammatory process. The work of Kamyshanov (2021) indicates a significant decrease in the parameters of the blood system in patients with latent mastitis cows. In this regard, biochemical studies of the blood serum of cows, carried out at the beginning of treatment and after a negative test for mastitis, indicate that when using a homeopathic preparation, there were qualitative changes in the protein, carbohydrate, and mineral metabolism in the body. The main positive point was the increase in the total protein index in the blood and the proportion of its globulin fractions, especially γ-globulins, which are responsible for the humoral mechanisms of the immune response to infection in animals (Bilyk et al., 2017). This could, in turn, be a decisive element in the treatment of the disease. In addition, the biologically active drugs contained in the preparation activated carbohydrate metabolism in the body and thereby increased the level of glucose in the blood, bringing it almost to the minimum physiological level. An increase in glucose in the blood serum can accelerate the reactivity of protective mechanisms and the migration of cellular immunity elements at the site of inflammation, which also contributed to the acceleration of the recovery of cows (Mylostyvyi et al., 2021a, 2021b). Also, a positive effect was an increase in the level of calcium in the blood, this reduced the porosity of the vessels and thereby reduced the degree of manifestation of the inflammatory process. Thus, the methods used in the experiment for the treatment of subclinical mastitis in cows had a high therapeutic result and are recommended for use in veterinary practice in this type of pathology. ConclusionBased on the research and analysis of publications on the issues of distribution, diagnosis, and treatment of subclinical mastitis in Kazakhstan and other countries, the following conclusions and proposals for future scientific work were made. Tests Kenotest, Somatest, mast dine test, and Whiteside method for the definition of animal diseases for subclinical mastitis in studies conducted in production conditions showed the same results. The efficiency of detecting the incidence of cows for latent mastitis was at the level of 60%–62%, with the control carried out using a settling test. The results obtained allow us to equally recommend these tests for use on dairy farms for the diagnosis of latent mastitis. The use of complex treatment of subclinical mastitis in animals allows you to speed up the recovery process by 2–4 days compared to the separate use of homeopathic medicines and physiotherapy. The use of the homeopathic preparation made it possible to accelerate the reduction in the number of somatic cells to a level not determined by the rapid test on days 4–8, which is 2–4 days earlier than the use of the traditional treatment regimen. In addition, the biologically active substances of medicinal plants used in the manufacture of homeopathic medicines have improved protein, carbohydrate, and mineral metabolism in animals. And it had a positive effect on the healing process. A significant increase in the level of the γ-globulin fraction in the blood serum of the cows of the experimental groups testified to the immunostimulating effect of the components of the homeopathic preparation, which also made it possible to speed up the healing process. The main therapeutic effect of microwave radiation obtained using the Aquaton-2 apparatus is its antimicrobial effect. The use of such a physical effect made it possible to reduce the number of mesophilic aerobic and facultative anaerobic microorganisms in milk by 1.5–5 times. At the same time, a positive correlation was noted between radiation exposure and the antimicrobial effect. Therefore, the goal of future research will be to determine the optimal time for using the Aquaton-2 device to obtain the maximum therapeutic effect. The limitations of this study include a small sample size, limited generalizability, the potential influence of unaccounted external factors, limitations in research design and data collection methods, and the absence of a control group in some comparisons. Future studies, it is planned to refine the diagnostic accuracy of rapid tests using the microscopic method of counting somatic cells as a control, followed by a comparison of their results. Since this is the reference method for determining mastitis. It is also planned to continue research using drug-free methods of treating subclinical mastitis in cows. AcknowledgmentsNone. Authors contributionsAigerim Kukeyeva, Talgat Abdrakhmanov, and Gulzhan Yeszhanova designed the study. Zhanar Bakisheva and Zhomart Kemeshov collected and analyzed the data. Zhomart Kemeshov wrote the manuscript. All authors reviewed and approved the final version. Conflict of interestThe authors have no conflicts of interest to disclose. FundingThis research received no external funding. Data availabilityData can be accessed by reaching out to the corresponding author. ReferencesAdkins, P.R.F. and Middleton, J.R. 2018. Methods for diagnosing mastitis. Vet. Clin. North Am. Food Anim. Pract. 34(3), 479–491. Ajose, D.J., Oluwarinde, B.O., Abolarinwa, T.O., Fri, J., Montso, K.P., Faymi, O.E., Aremu, A.O. and Ateba, C.N. 2022. Combating bovine mastitis in the dairy sector in an era of antimicrobial resistance: ethno-veterinary medicinal option as a viable alternative approach. Front. Vet. Sci. 9, 800322. Antanaitis, R., Juozaitien, Е.V., Jonike, V., Baumgartner, W. and Paulauskas, A. 2021. Milk lactose as a biomarker of subclinical mastitis in dairy cows. Animals 11(6), 1736. Bilyk, O., Slyvka, N., Gutyj, B., Dronyk, H. and Sukhorska, O. 2017. Substantiation of the method of protein extraction from sheep and cow whey for producing the cheese «urda». East. Eur. J. Enterp. Technol. 3(11–87), 18–22. Borne, B.H.P., Schaik, G., Lam, T.J.G.M., Nielen, M. and Frankena, K. 2019. Intramammary antimicrobial treatment of subclinical mastitis and cow performance later in lactation. J. Dairy Sci. 102(5), 4441–4451. Bulegenova, M., Biyashev, K., Kirkimbaeva, Z., Biyashev, B., Ermagambetova, S., Oryntayev, K. and Altenov, A. 2019. The effect of the drug enterocol on the humoral factors of calf body resistance. Adv. Anim. Vet. Sci. 7(8), 674–680. Chernenok V.V., Tkachev M.A. and Chernenok Y.U.N. 2019. The effectiveness of different methods for diagnosing mastitis in cows. Bull. FGOU VPO Bryansk State Agric. Acad. 74, 15–18. Chuzhebayeva, G.D., Nametov, A.M., Beyshova, I.S., Nurgaliyev, B.Y., Ulyanov, V.A., Ulyanova, T.V. and Aliyeva, G.K. 2021. Species composition of pathogens and assessment of production losses in case of subclinical mastitis of cows in the farms of the Kostanay region (Kazakhstan). Bull. Krasnoyarsk State Agrar. Univ. 11(176), 116–122. Costa, A., De Marchi, M., Neglia, G., Campanile G. and Penasa, M. 2021. Milk somatic cell count-derived traits as new indicators to monitor udder health in dairy buffaloes. Ital. J. Anim. Sci. 20(1), 548–558. Dikhanbayeva, F., Zhaksylykova, G., Syzdykova, L., Smailova, Z. and Tasturganova, E. 2019. Production of a dairy product based on camel milk for special purposes. Period. Tche Quim. 16(33), 241–247. Ebrahimie, E., Ebrahimi, F., Ebrahimi, M., Tomlinson, S. and Petrovski, K.R. 2018. A large-scale study of indicators of sub-clinical mastitis in dairy cattle by attribute weighting analysis of milk composition features: highlighting the predictive power of lactose and electrical conductivity. J. Dairy Res. 85(2), 193–200. Gritsienko, Y., Gill, M. and Karatieievа, O. 2022. Connection between gene markers with milk production traits of Ukrainian dairy cows. Online J. Anim. Feed Res. 12(5), 302–313. Gryshchenko, V.A., Chernyshenko, T.M., Gornitska, O.V. and Platonova, T.M. 2016. Evaluation of the functional state of liver and the efficiency of therapy for enteropathy of calves. Fiziolohich. Zhurn. 62(6), 102–109. Imam, B.H., Oladejo, A.O., Wu, X., Yang, J., Ma, X., Shen, W., Wei, J., Yan, Z. and Ding, X. 2021. Anti-inflammatory and antibacterial potential of Qicao Rukang powder in bovine subclinical mastitis. Evid. Based Complement. Altern. Med. 2021, 2148186. Kamyshanov, A.S. 2021. The study of biochemical and morphological parameters of the blood of cows with mastitis in different periods of lactation. Agris, 2021(3105), 151–152. Kandeel, S.A., Megahed, A.A., Ebeid, M.H. and Constable, P.D. 2019. Ability of milk pH to predict subclinical mastitis and intramammary infection in quarters from lactating dairy cattle. J. Dairy Sci. 102(2), 1417–1427. Kandeel, S., Morin, D., Calloway, C. and Constable, P. 2018. Association of California mastitis test scores with intramammary infection status in lactating dairy cows admitted to a Veterinary Teaching Hospital. J. Vet. Intern. Med. 2, 497–505. Kelm, D. 2021. Innovative methods will drive growth in milk production. Available via https://kazakh-zerno.net/186826-innovacionnye-metody-budut-stimulirovat-rost-proizvodstva-moloka/ (Accessed 14 January 2023). Khastayeva, A.Z., Zhamurova, V.S., Mamayeva, L.A., Kozhabergenov, A.T., Karimov, N.Z. and Muratbekova, K.M. 2021. Qualitative indicators of milk of Simmental and Holstein cows in different seasons of lactation. Vet. World 14(4), 956–963. Kumari, T., Bhakat, C. and Choudhary, R.K. 2018. A Review on sub clinical mastitis in dairy cattle. Int. J. Pure Appl. Biosci. 6(2), 1291–1299. Larionov, G.A., Semenov, V.G., Baimukanov, D.A., Kosyaev, N.I., Alekseev, I.A., Nikitin, D.A. and Karynbayev, A.K. 2019. The role of plant preparations in improving the safety and quality of milk in subclinical mastitis of cows. Bull. Natl. Acad. Sci. Republic Kazakhstan 1, 151–161. Laushkina, N.N., Skrebnev, S.A. and Skrebneva, K.S. 2020. Methods for diagnosing subclinical mastitis of cows during the lactation period in a dairy complex. Bull. Orel State Agrar. Univ. 6(87), 61–65. Leitner, G., Lavon, Y., Merin, U., Jacoby, S., Blum, S. E., Krifucks, O. and Silanikove, N. 2019. Milk quality and milk transformation parameters from infected mammary glands depends on the infecting bacteria species. PLoS One 14(7), e0213817. Leitner, G., Papirov, E., Gilad, D., Haran, D., Arkin, O., Zuckerman, A. and Lavon, Y. 2021. New treatment option for clinical and subclinical mastitis in dairy cows using acoustic pulse technology (APT). Dairy 2(2), 256–269. Lubimov, V., Romanov, D., Tsoi, Y., Ziganshin, B. and Sitdikov, F. 2020. Results of application of frequency resonance therapy for treatment of cow mastitis. BIO Web Conf. 17, 00254. McDougall, S., Clausen, L.M., Hussein, H.M. and Compton, C.W.R. 2022. Therapy of subclinical mastitis during lactation. Antibiotics 11(2), 209. Mironchik, S.V. and Babayants, N.V. 2021. Current trends in the treatment of cows with mastitis. Actual Probl. Intensive Dev. Anim. Husbandry 24(2), 277–285. Moreira, L.H., Souza, J.C.P., Lima, C.J., Salgado, M.A.C., Fernandes, A.B., Andreani, D.I.K., Villaverde, A.B. and Zangaro, R.A. 2018. Use of photodynamic therapy in the treatment of bovine subclinical mastitis. Photodiagn. Photodyn. Ther. 21, 246–251. Mukhamadieva, N., Julanov, M., Zainettinova, D., Stefanik, V., Nurzhumanova, Z., Mukataev, A. and Suychinov, A. 2022. Prevalence, diagnosis and improving the effectiveness of therapy of mastitis in cows of dairy farms in East Kazakhstan. Vet. Sci. 9(8), 398. Mustafin, A.T. and Volkov, E.I. 1984. The role of lipid and antioxidant exchanges in cell division synchronization (mathematical model). Biol. Cybernet. 49(3), 149–154. Mylostyvyi, R., Lesnovskay, O., Karlova, L., Khmeleva, O., Kalinichenko, O., Orishchuk, O., Tsap, S., Begma, N., Cherniy, N., Gutyj, B. and Izhboldina, O. 2021a. Brown Swiss cows are more heat resistant than Holstein cows under hot summer conditions of the continental climate of Ukraine. J. Anim. Behav. Biometeorol. 9(4), 2134. Mylostyvyi, R., Sejian, V., Izhboldina, O., Kalinichenko, O., Karlova, L., Lesnovskay, O., Begma, N., Marenkov, O., Lykhach, V., Midyk, S., Cherniy, N., Gutyj, B. and Hoffmann, G. 2021b. Changes in the spectrum of free fatty acids in blood serum of dairy cows during a prolonged summer heat wave. Anim. 11(12), 3391. Nagasawa, Y., Kiku, Y., Sugawara, K., Yabusaki, N., Oono, K., Fujii, K., Suzuki, T., Maehana, K. and Hayashi, T. 2020. Rapid Staphylococcus aureus detection from clinical mastitis milk by colloidal gold nanoparticle-based immunochromatographic strips. Front. Vet. Sci. 6, 504. Neculai-Valeanu, A. S., Ariton, A. M. 2022. Udder health monitoring for prevention of bovine mastitis and improvement of milk quality. Bioengineering 9(11), 608. Niyongabo, H., Shunaeva, A.V. and Gavrilov, B.V. 2021. Comparative analysis of methods for early detection of subclinical mastitis in cows. In Scientific Support of the Agro-industrial Complex. Krasnodar, Russia: Kuban State Agrarian University named after I.T. Trubilin, pp: 208–211. Proshutinskaya, Y.U.S. and Neverova, O.P. 2019. Somatic cells in cow milk as an indicator of its quality. Youth Sci. 3, 84–84. Rahimzhanova, D.T., Yeszhanova, G.T. and Kukeeva, A.A. 2020. Effectiveness of the application of the “Aquaton-02” device for subclinical mastitis of cows. Intellect, Idea, Innovation 2, 42–48. Ranasinghe, R.M., Deshapriya, R.M.C., Abeygunawardana, D.I., Rahularaj, R. and Dematawewa, C.M.B. 2021. Subclinical mastitis in dairy cows in major milk-producing areas of Sri Lanka: prevalence, associated risk factors, and effects on reproduction. J. Dairy Sci. 104(12), 12900–12911. Regulation (EC) No. 853/2004 of the European Parliament and of the Council of 29 April 2004 laying down specific hygiene rules for food of animal origin. 2021. Available via http://data.europa.eu/eli/reg/2004/853/oj (Accessed 25 January 2023). Rienesl, L., Khayatzdadeh, N., Kock, A., Egger-Danner, C., Gengler, N., Grelet, C., Dale, L. M., Werner, A., Auer, F.J., Leblois, J. and Solkner, J. 2022. Prediction of acute and chronic mastitis in dairy cows based on somatic cell score and mid-infrared spectroscopy of milk. Animals 12(14), 1830. Robles, I., Nolan, D.T., Fendley, C.A., Stokley, H.L., France, T.L., Ferrell, J.L. and Costa, J.H.C. 2021. Technical note: evaluation of a commercial on-farm milk leukocyte differential tester to identify subclinical mastitis cases in dairy cows. J. Dairy Sci. 104(4), 4942–4949. Rychshanova, R., Mendybayeva, A., Miciński, B., Mamiyev, N., Shevchenko, P., Bermukhametov, Z., Orzechowski, B. and Miciński, J. 2022. Antibiotic resistance and biofilm formation in Staphylococcus aureus isolated from dairy cows at the stage of subclinical mastitis in northern Kazakhstan. Arch. Anim. Breed. 65(4), 439–448. Semivolos A.M. 2011. Development of a new drug-free method of treating cows with subclinical mastitis. Bull. Orel State Agrar. Univ. 30(1), 84–85. Shakhnovich, V.C. 2020. Rapid tests for the diagnosis of mastitis in cows. Available via https://www.belagrogen.by/inform/blog/143-ekspres-testy-dlya-diagnostiki-mastita-u-korov.html (Accessed 02 February 2023). Sharun, K., Dhama, K., Tiwari, R., Bashir Gugjoo, M., Yatoo, M.I., Patel, S., Pathak, M., Karthik, K., Khurana, S.K., Singh, R., Amarpal, B., Singh, R., Singh, K.P. and Chaicumpa, W. 2021. Advances in therapeutic and managemental approaches of bovine mastitis: a comprehensive review. Vet. Q. 41(1), 107–136. Shukesheva, S.E., Uzakov, Y.M., Chernukha, I.M., Nurmukhanbetova, D.E., Nabiyeva, Z.S. and Nurtaeva, A.B. 2018. Research to improve the quality of food products. News Natl. Acad. Sci. Republic Kazakhstan Ser. Geol. Tech. Sci. 3(430), 37–45. Sinha, R., Bhakat, M., Mohanty, T.K., Ranjan, A., Kumar, R., Lone, S.A. and Danish, Z. 2018. Infrared thermography as non-invasive technique for early detection of mastitis in dairy animals—a review. Asian J. Dairy Food Res. 37(1), 1–6. ST RK 1760-2008. State Standard of the Republic of Kazakhstan. Cow’s milk. Specifications. 2008. Available via https://files.stroyinf.ru/Data2/1/4293740/4293740510.pdf (Accessed 13 February 2023). Technical Regulations of the Customs Union “On the safety of milk and dairy products.” TR TS 033/2013. 2013. Available via http://dairyunion.ru/wp-content/uploads/2015/05/Tex_reglament_moloko033.pdf (Accessed 13 February 2023). Velasco-Bolanos, J., Ceballes-Serrano, C.C., Velasquez-Mejia, D., Riano-Rojas, J.C., Giraldo, C.E., Carmona, J.U. and Ceballos-Marquez, A. 2021. Application of udder surface temperature by infrared thermography for diagnosis of subclinical mastitis in Holstein cows located in tropical highlands. J. Dairy Sci. 104(9), 10310–10323. Williamson, J., Callaway, T., Rollin, E. and Ryman, V. 2022. Association of milk somatic cell count with bacteriological cure of intramammary infection—a review. Agriculture 12(9), 1437. Yang, W.T., Ke, C.Y., Wu, W.T., Lee, R.P. and Tseng, Y.H. 2019. Effective treatment of bovine mastitis with intramammary infusion of Angelica dahurica and Rheum officinale extracts. Evid. Based Complement. Altern. Med. 2019, 7242705. Zainettinova, D.B., Muhamadieva, N.N., Julanov, M.N., Stefanyk, V.Y., Zaviruha, V.I. and Sarhambaeva, I.A. 2019. The effectiveness of the treatment of cows with mastitis. Sci. Messenger Lviv Natl. Univ. Vet. Med. Biotechnol. Ser. Vet. Sci. 21(94), 78–81. Zecconi, A., Vairani, D., Cipolla, M., Rizzi, N. and Zanini, L. 2019. Assessment of subclinical mastitis diagnostic accuracy by differential cell count in individual cow milk. Ital. J. Anim. Sci. 18(1), 460–465. Zhelavskyi, M. 2021. The role of neutrophil on subclinical mastitis in cows. Pol. J. Nat. Sci. 36(1), 107–115. Zhumanov, K.T., Biyashev, K.B., Biyashev, B.K., Sansyzbai, A.R. and Valdovska, A. 2015. Application of polyvalent hyperimmune serum against mastitis in beef cattle. Biol. Med. 7(5), BM-154-15. | ||
| How to Cite this Article |
| Pubmed Style Kukeyeva A, Abdrakhmanov T, Yeszhanova G, Bakisheva Z, Kemeshov Z. The use of a homeopathic preparation in the treatment of subclinical form of mastitis in cows. Open Vet. J.. 2023; 13(8): 991-1002. doi:10.5455/OVJ.2023.v13.i8.5 Web Style Kukeyeva A, Abdrakhmanov T, Yeszhanova G, Bakisheva Z, Kemeshov Z. The use of a homeopathic preparation in the treatment of subclinical form of mastitis in cows. https://www.openveterinaryjournal.com/?mno=150661 [Access: June 22, 2026]. doi:10.5455/OVJ.2023.v13.i8.5 AMA (American Medical Association) Style Kukeyeva A, Abdrakhmanov T, Yeszhanova G, Bakisheva Z, Kemeshov Z. The use of a homeopathic preparation in the treatment of subclinical form of mastitis in cows. Open Vet. J.. 2023; 13(8): 991-1002. doi:10.5455/OVJ.2023.v13.i8.5 Vancouver/ICMJE Style Kukeyeva A, Abdrakhmanov T, Yeszhanova G, Bakisheva Z, Kemeshov Z. The use of a homeopathic preparation in the treatment of subclinical form of mastitis in cows. Open Vet. J.. (2023), [cited June 22, 2026]; 13(8): 991-1002. doi:10.5455/OVJ.2023.v13.i8.5 Harvard Style Kukeyeva, A., Abdrakhmanov, . T., Yeszhanova, . G., Bakisheva, . Z. & Kemeshov, . Z. (2023) The use of a homeopathic preparation in the treatment of subclinical form of mastitis in cows. Open Vet. J., 13 (8), 991-1002. doi:10.5455/OVJ.2023.v13.i8.5 Turabian Style Kukeyeva, Aigerim, Talgat Abdrakhmanov, Gulzhan Yeszhanova, Zhanar Bakisheva, and Zhomart Kemeshov. 2023. The use of a homeopathic preparation in the treatment of subclinical form of mastitis in cows. Open Veterinary Journal, 13 (8), 991-1002. doi:10.5455/OVJ.2023.v13.i8.5 Chicago Style Kukeyeva, Aigerim, Talgat Abdrakhmanov, Gulzhan Yeszhanova, Zhanar Bakisheva, and Zhomart Kemeshov. "The use of a homeopathic preparation in the treatment of subclinical form of mastitis in cows." Open Veterinary Journal 13 (2023), 991-1002. doi:10.5455/OVJ.2023.v13.i8.5 MLA (The Modern Language Association) Style Kukeyeva, Aigerim, Talgat Abdrakhmanov, Gulzhan Yeszhanova, Zhanar Bakisheva, and Zhomart Kemeshov. "The use of a homeopathic preparation in the treatment of subclinical form of mastitis in cows." Open Veterinary Journal 13.8 (2023), 991-1002. Print. doi:10.5455/OVJ.2023.v13.i8.5 APA (American Psychological Association) Style Kukeyeva, A., Abdrakhmanov, . T., Yeszhanova, . G., Bakisheva, . Z. & Kemeshov, . Z. (2023) The use of a homeopathic preparation in the treatment of subclinical form of mastitis in cows. Open Veterinary Journal, 13 (8), 991-1002. doi:10.5455/OVJ.2023.v13.i8.5 |